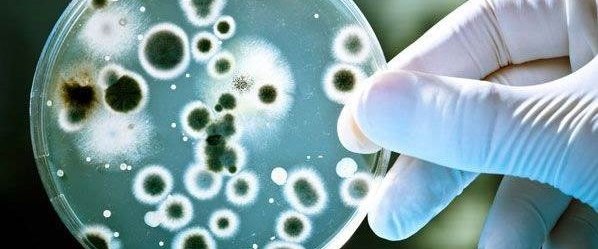
Antibiyotiklere dirençli bakteri tehdidi.jpeg

![]()
Antibiyotiklere dirençli bakterilerle mücadelede yeni bir adım atıldı. Birleşmiş Milletlere üye ülkeler insanlığa yönelik en büyük tehditlerden biri olarak kabul edilen dirençli bakterilerle mücadelede ortak hareket etme kararı aldı.
Antibiyotiklere dirençli bakteriler insanlığı tehdit ediyor.
Bu sorun, Birleşmiş Milletler Genel Kurul toplantılarında da gündemdeydi.
Birleşmiş Milletler’e üye 193 ülke, dirençli bakterilere karşı işbirliği kararı aldı.
Birleşmiş Milletler Genel Sekreteri Ban Ki-Moon, “Dirençli bakteriler sürdürülebilir büyüme hedeflerini sekteye uğratıyor” diyerek sorunun ekonomik boyutuna dikkat çekti.
Dünya Bankası da genel sekreterin açıklamasına paralel olarak bu sorunun BM’nin 2030 yılı büyüme hedeflerine ulaşmasına engel olacağını açıkladı.
TIP DÜNYASI ÇARESİZ KALABİLİR
Bakterilerin tedavilere tamamen direnç geliştirilmesiyle tıp biliminin karanlık çağlara sürüklenebileceğinden kaygı duyuluyor.
Bu durumda sık görülen ve antibiyotikle tedavi edilen basit enfeksiyonların yeniden can almaya başlayabileceğine dikkat çekiliyor. Antibiyotiklerin kullanıldığı ameliyat sonrası bakım ve kanser tedavilerinin de risk altına girebileceği belirtiliyor.

POLİTİKACILAR, DOKTORLAR, İLAÇ VE GIDA ENDÜSTRİSİ BİRLİKTE ÇALIŞMALI
Dünyada dirençli bakterilerin her yıl 700 bin kişinin ölümüne neden olduğu tahmin ediliyor.
Sorunla mücadelede politikacıların, ilaç ve gıda endüstrilerinin ve doktorların ortak hareket etmesi gerekiyor.
Dünya Sağlık Örgütü doktorlara, uygulanabilir bir önlem olarak, reçetelerinde antibiyotiğe daha az yer vermeleri tavsiyesinde bulunuyor.
